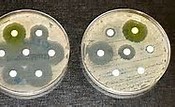

最近抗生素问题多次出现,全国乃至全球都引起了重视!2月27日发表了全球首份抗生素耐药“重点病原体”清单,即对人类健康构成最大威胁的12种细菌种族的目录!抗生素的滥用同时也导致超级细菌的出现!为了健康别再用抗生素了,分享给你爱的人!
世界卫生组织27日发布首份急需新型抗生素的重点病原体清单,旨在指导和促进新型抗生素的研究与开发。因出现抗生素耐药性问题且对人类健康构成重要威胁,12种细菌种族入列该清单。
其中,最迫切需要研发新型抗生素的细菌种族为不动杆菌属、假单胞菌属和各种肠杆菌科。不动杆菌属细菌和假单胞菌属细菌已对碳青霉烯类抗生素产生了耐药性,肠杆菌科细菌则对碳青霉烯类抗生素和第三代头孢菌素类抗生素产生了耐药性。这些细菌可引起肺炎、脑膜炎、菌血症、痢疾等疾病。
世卫组织负责卫生系统和创新事务的助理总干事基尼(Marie-Paule Kieny)27日在日内瓦向媒体通报指出,抗生素耐药性问题不断加重,人类的治疗选用办法正在快速耗尽。如果仅仅依靠市场力量来解决问题,最迫切需要的新型抗生素将不会得到及时开发。此次发布的清单是用来确保研发工作面向公共卫生紧急需求的新工具。
益生菌——抗生素的理想替代品
抗生素的危害日益严重,过度使用会给人体带来更大伤害,但是家人患了细菌性疾病——下呼吸道感染咳嗽、发热、支气管炎反复发作,不得不使用抗生素,那应该怎么办呢!
这种情况下给患者补充益生菌就十分必要了,作为抗生素的理想替代品,益生菌不仅可调节呼吸系统菌群平衡,及时搞定因为抗生素导致的呼吸道菌群紊乱,帮助呼吸系统正常工作。
益清美X益生菌就是这样的治疗性功能益生菌。益清美X台湾原装进口,是专门针对呼吸系统疾病的致发炎有害菌培养提取的有益菌。益清美X含有鼠李糖乳杆菌L. rhamnosus ct-53、副干酪乳杆菌L. paracasei MP137、嗜热链球菌S.thermophilusSY-66三大专利菌株,不仅能有效杀灭流感病毒、奈瑟球菌、肺炎球菌、流感杆菌、大肠杆菌等支气管致发炎细菌和病毒,还能增加气管、支气管的粘液屏障功能,在支气管粘膜层形成保护层,提高从咽喉到气管和肺部的免疫技能,阻止细菌病毒进入呼吸系统,真正终结多种呼吸问题。

益清美X菌株供应商为台湾丰华,这是全亚洲最大的益生菌生产研发基地,菌株的活性、质量、效果都是有保证的。益清美X的菌株都是经过了专利认证的,而且是大陆和台湾的双专利认证,因此菌株的活性和效果都有保证。益清美X独有三大专利菌株“鼠李糖乳杆菌L. rhamnosus ct-53、副干酪乳杆菌L. paracasei MP137、嗜热链球菌S.thermophilusSY-66”,全部是专门针对下呼吸道炎症的有益菌,每种益生菌都有自己独特的功效,配比在一起更是加倍的效果。
如果你已经尝试过市面上和医院为你提供的一切方法,但是仍旧无法消除支气管炎,你可以考虑替代疗法——用益生菌治疗感染。它可以解决抗生素的副作用,减少其对患者身体危害,与此同时,益清美X益生菌还可刺激肠道、呼吸道黏膜派遣大量抗体,增强人体免疫力,大大增强治疗效果,特别是免疫力低下易感冒,咳嗽、咳痰、喘息反复发作的人群。益清美X益生菌不是药物但是胜似药物,非抗生素,无任何副作用,成人、老人、孕妇、儿童都可使用,是国内唯一的呼吸功能益生菌产品。
本网站所载的文/图等稿件均出于为公众传播有益健康的信息之目的,并不意味着赞同其观点或证实其内容的真实性,我们不对其科学性、严肃性等作任何形式的保证。如其他媒体、网络或个人从本网下载使用须自负版权等法律责任。
本网站所有信息仅供参考,不做个别诊断、用药和使用的根据。本网站致力于提供正确、完整的健康资讯,但不保证信息的正确性和完整性,且不对因信息的不正确或遗漏导致的任何损失或损害承担责任。本站所提供的任何医药资讯,仅供参考,不能替代医生和其他医务人员的建议,如自行使用本网资料发生偏差,本站概不负责,亦不负任何法律责任。
